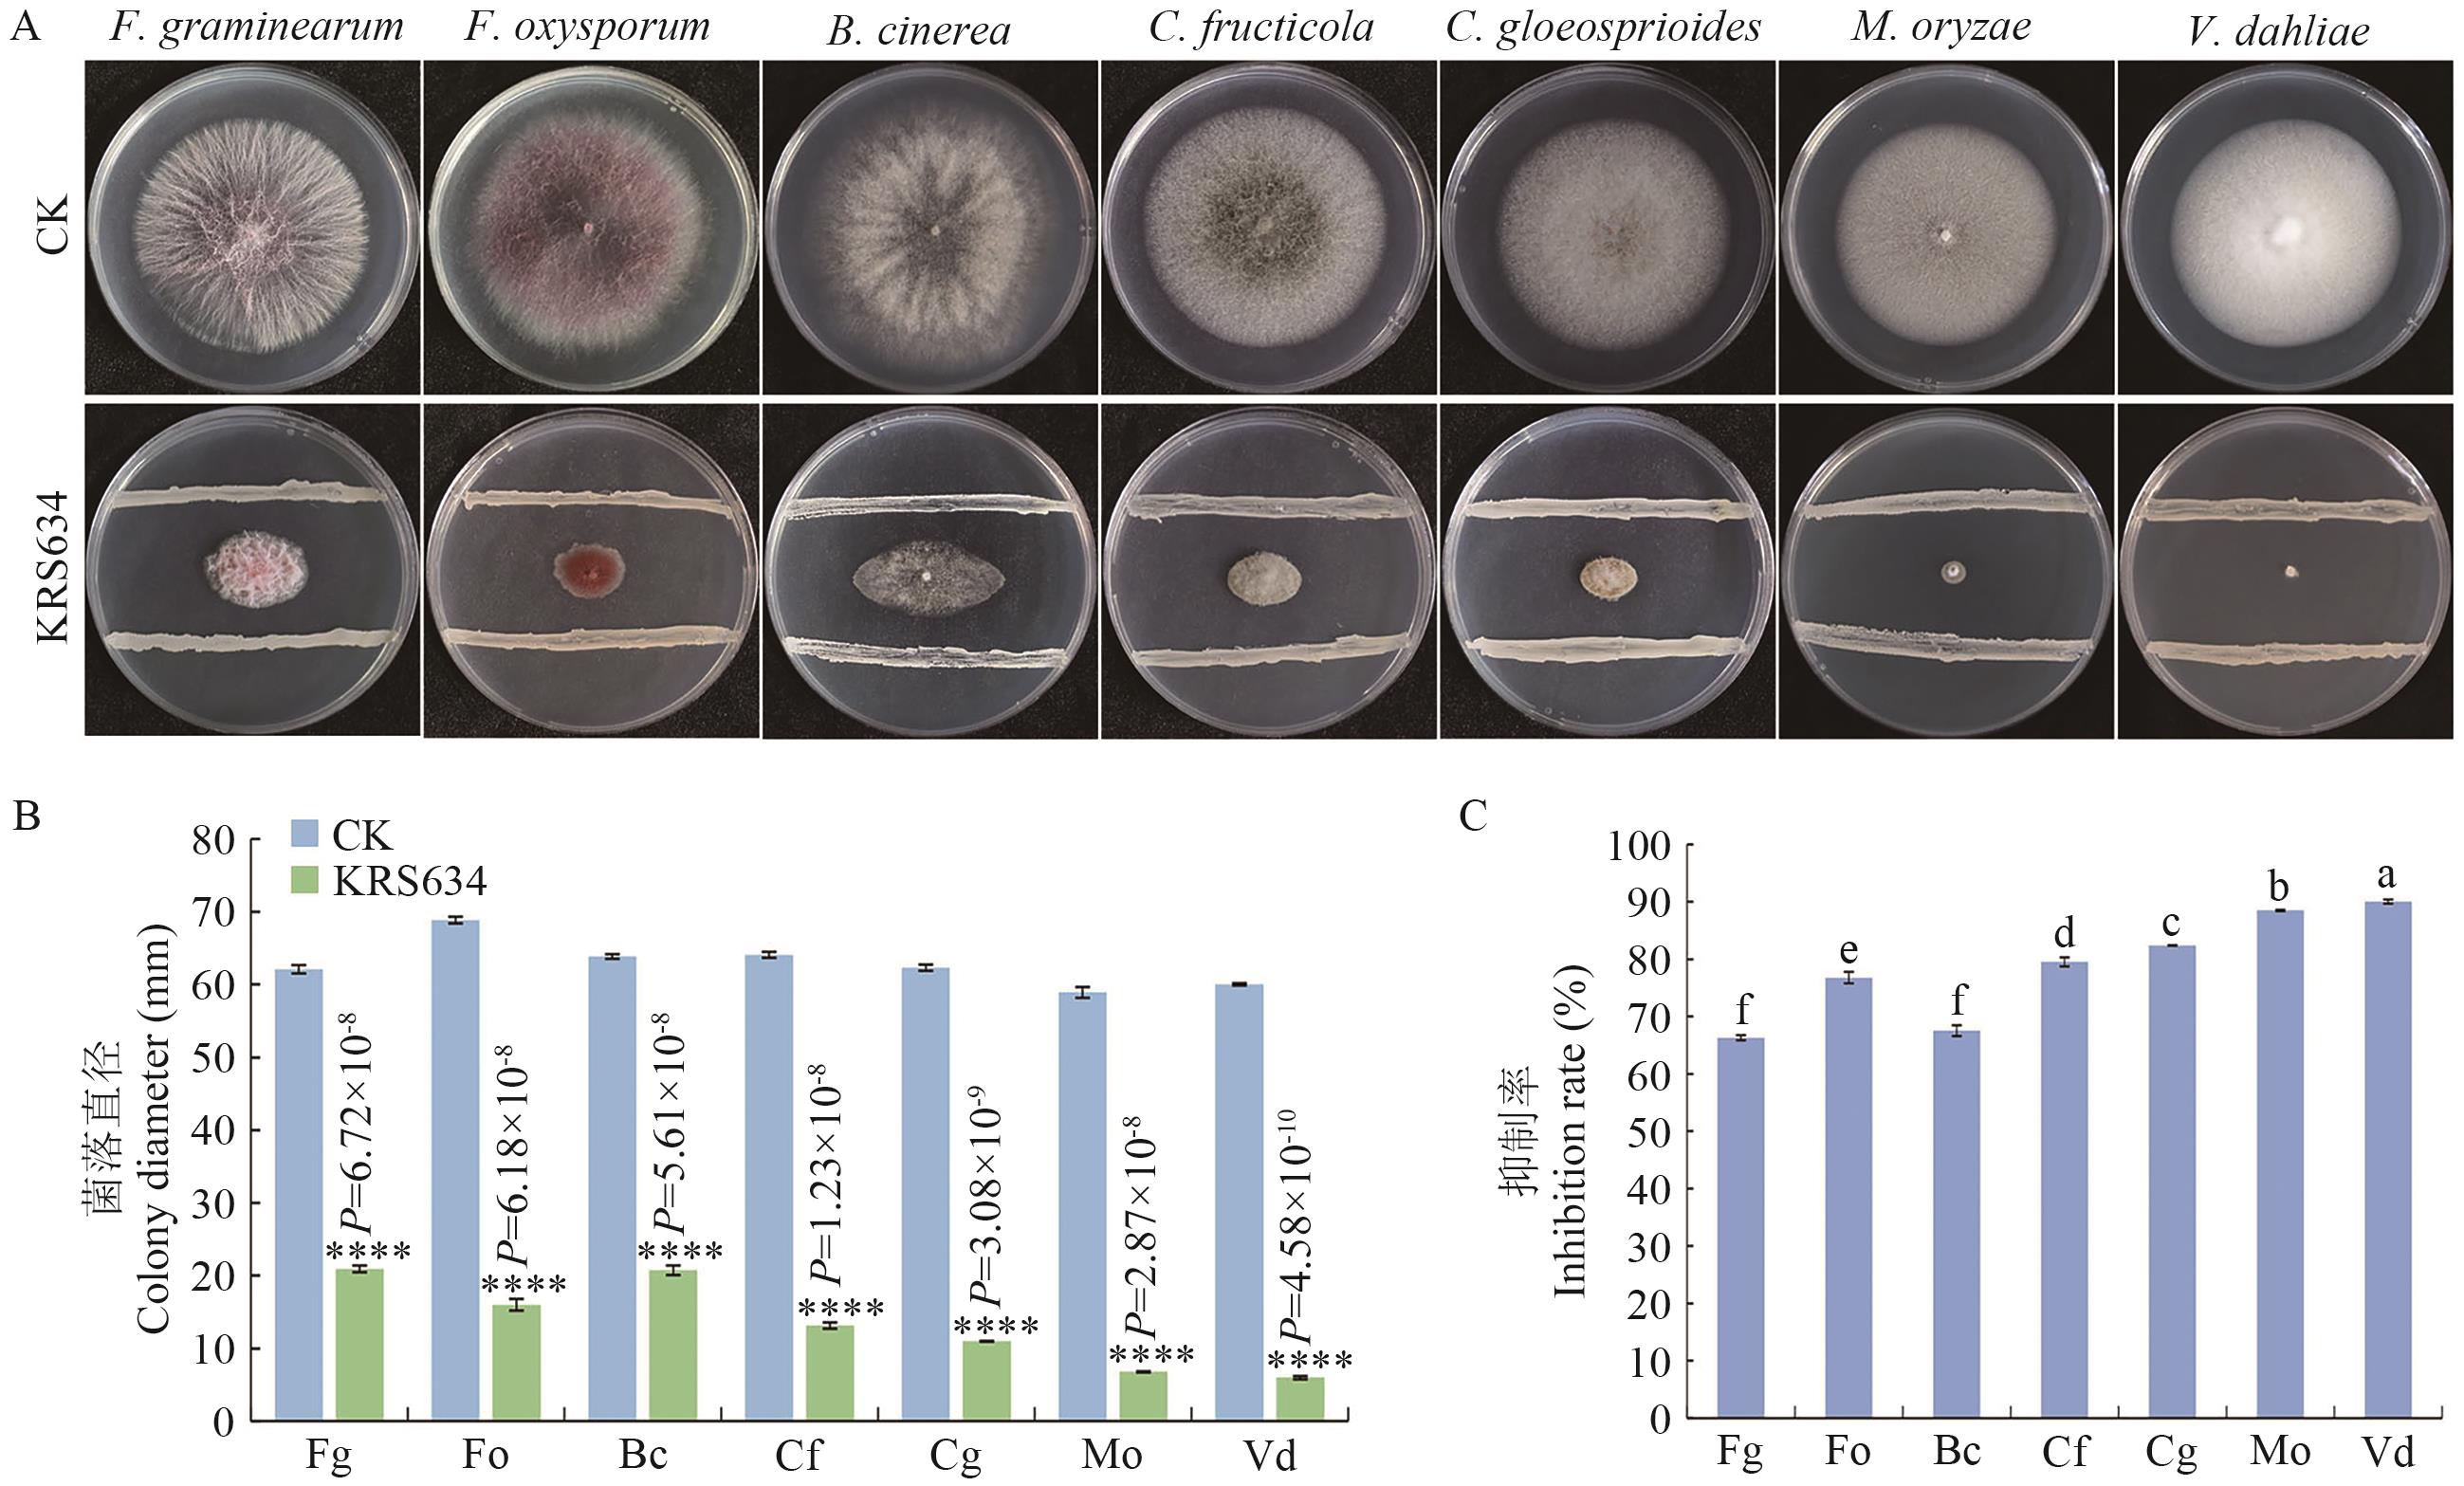
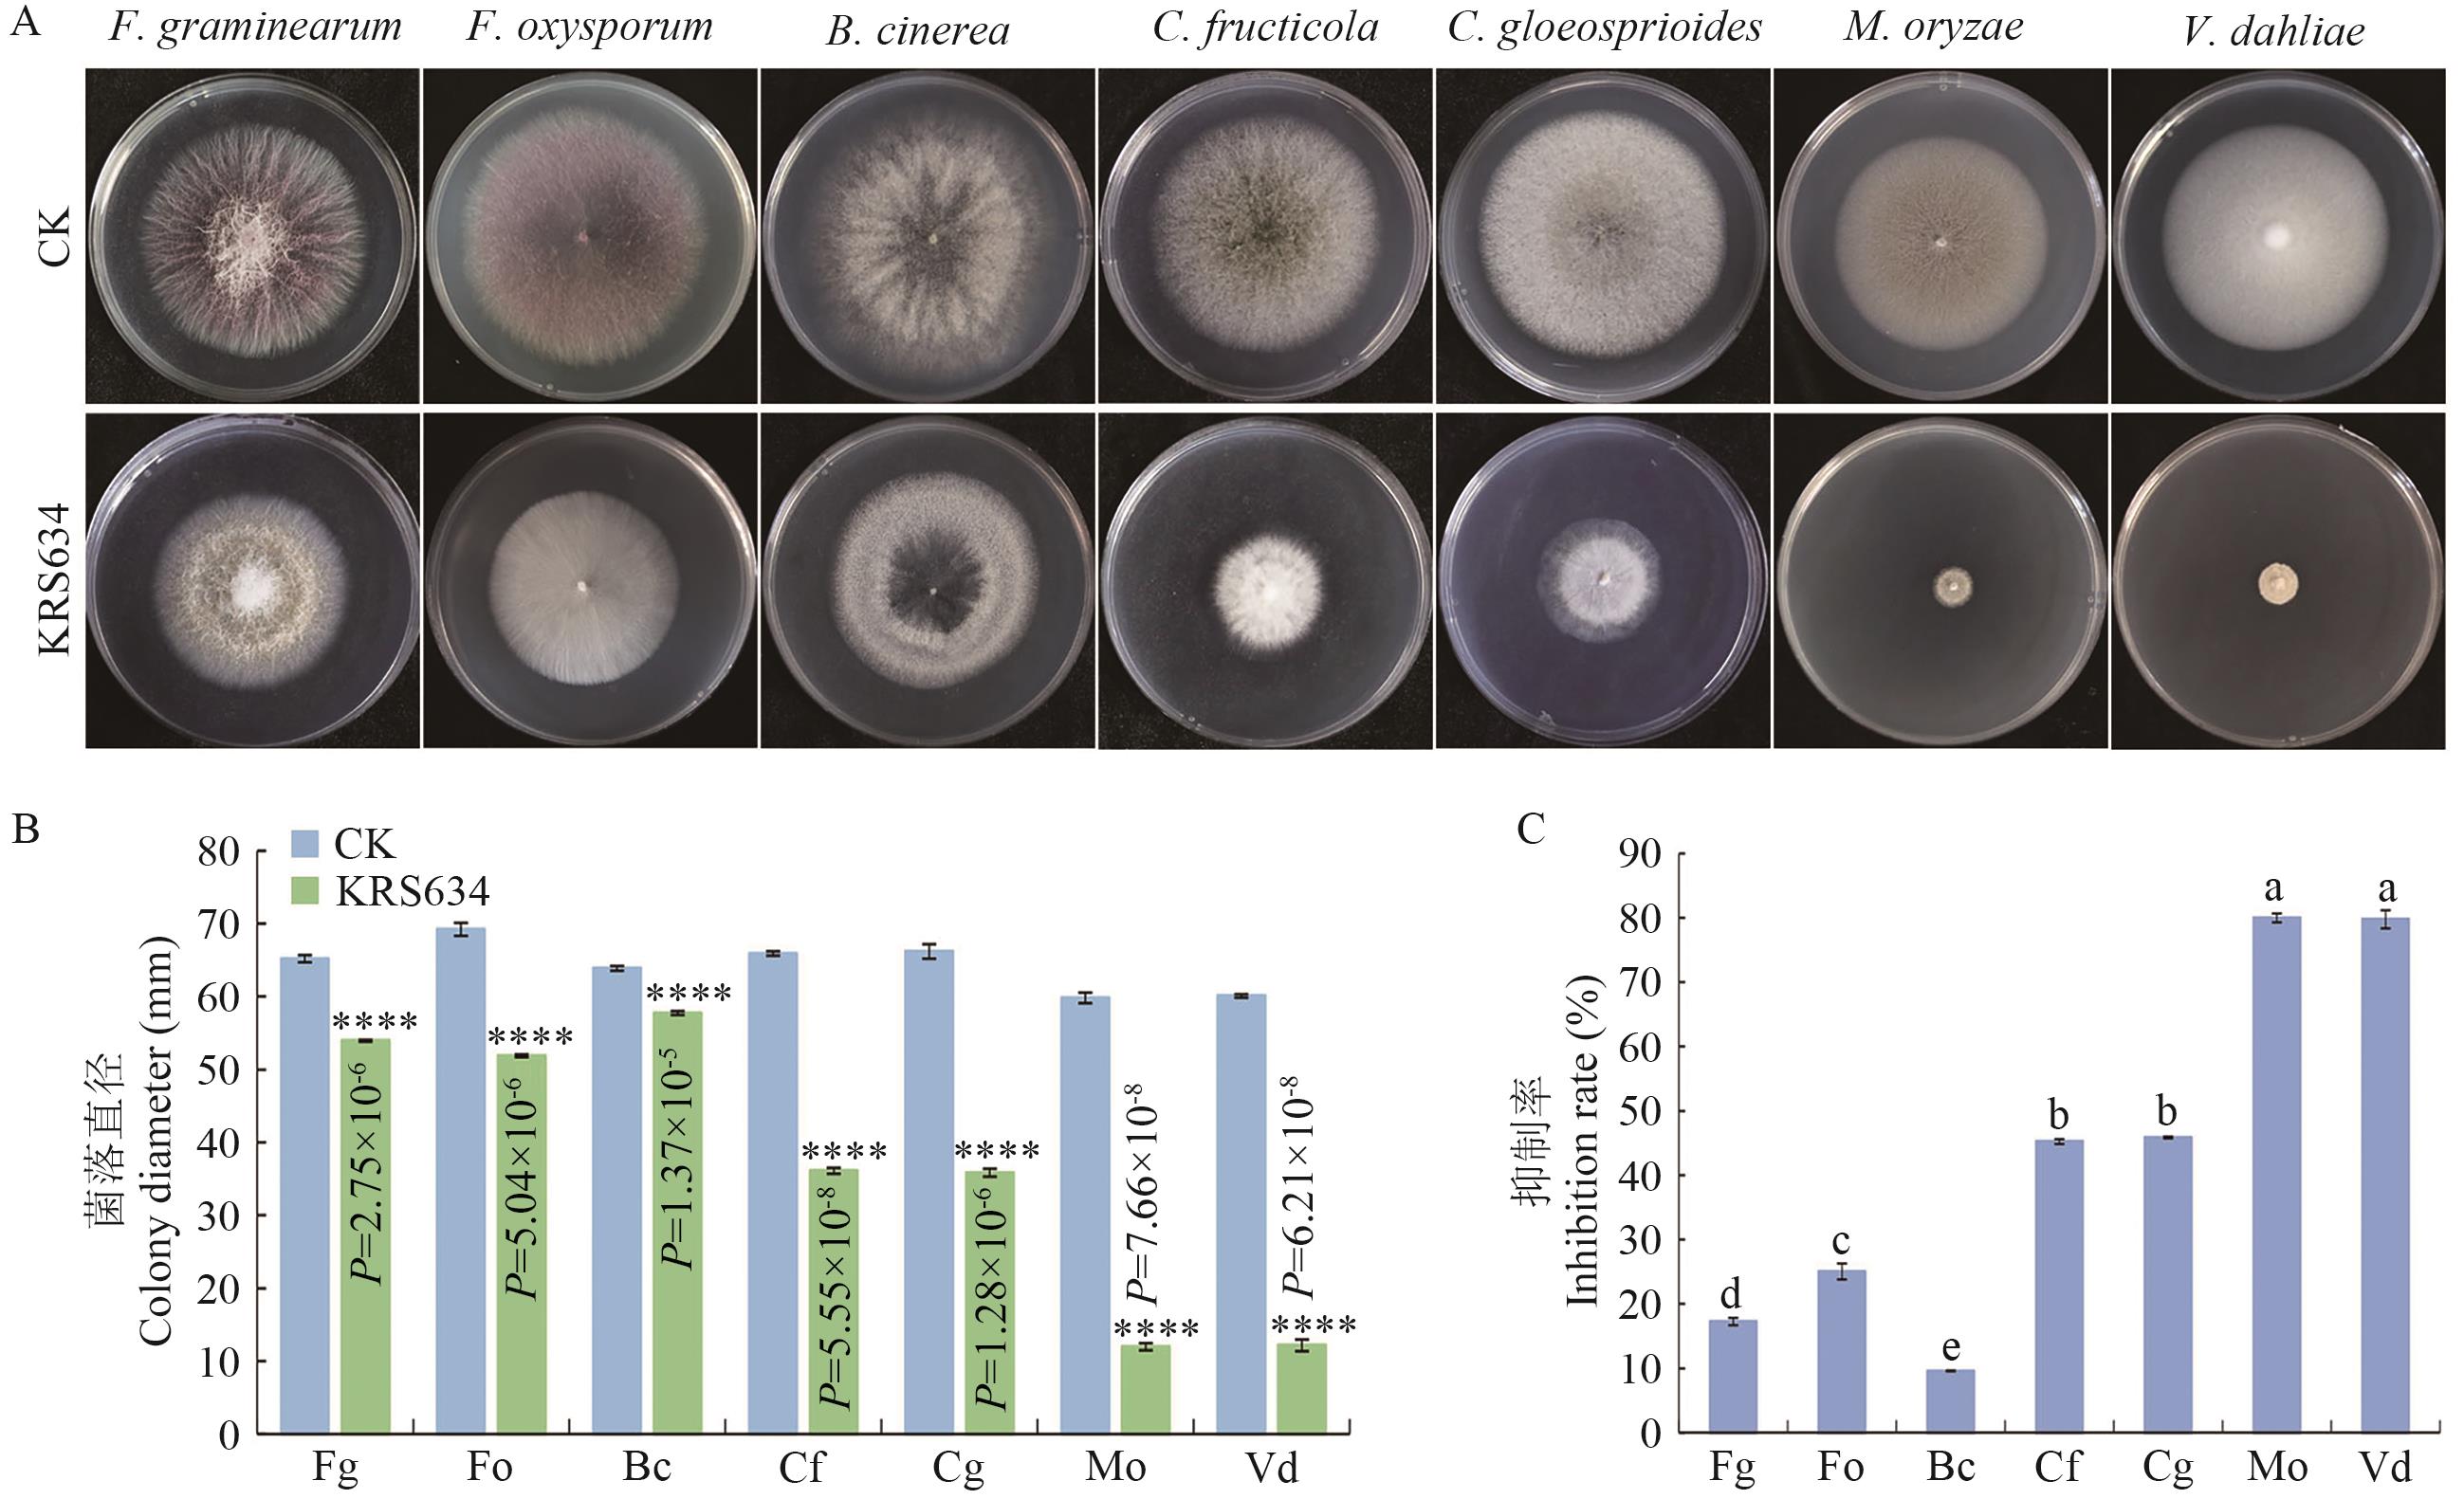

生物技术通报 ›› 2025, Vol. 41 ›› Issue (12): 294-303.doi: 10.13560/j.cnki.biotech.bull.1985.2025-0497
吴琼1,2( ), 陈德勇3, 朱鹤4, 王丹5, 张晓军1(
), 陈德勇3, 朱鹤4, 王丹5, 张晓军1( ), 陈捷胤2(
), 陈捷胤2( )
)
收稿日期:2025-05-14
出版日期:2025-12-26
发布日期:2026-01-06
通讯作者:
陈捷胤,男,博士,研究员,研究方向 :植物病理学;E-mail: chenjieyin@caas.cn作者简介:吴琼,女,硕士,研究方向 :植物学;E-mail: 875031242@qq.com
基金资助:
WU Qiong1,2( ), CHEN De-yong3, ZHU He4, WANG Dan5, ZHANG Xiao-jun1(
), CHEN De-yong3, ZHU He4, WANG Dan5, ZHANG Xiao-jun1( ), CHEN Jie-yin2(
), CHEN Jie-yin2( )
)
Received:2025-05-14
Published:2025-12-26
Online:2026-01-06
摘要:
目的 获得绿色、安全、高效的对棉花红腐病具有良好防效的生防菌剂。 方法 以拟轮枝镰孢霉Fusarium verticillioides为靶标菌,通过平板对峙法筛选拮抗菌株,通过形态观察、16S rRNA序列的系统发育分析及促生特性对菌株进行鉴定分析;采用盆栽试验进一步测定菌株生防及促生效果;采用对峙培养法和对扣熏蒸法测试菌株对多种真菌的抑制作用。 结果 洋葱伯克霍尔德氏菌(Burkholderia contaminans)KRS634对F. verticillioides的抑菌率为73.80%;该菌株具有解磷、解钾、固氮及产嗜铁素的促生特性;室内防效试验表明,KRS634能够有效降低棉花苗期红腐病的发生,经KRS634处理的棉花红腐病病株率为85.71%,病情指数为36.31,显著低于对照组;KRS634发酵液还能够提高棉花出苗率,促进棉花生长;另外,KRS634对大丽轮枝菌(Verticillium dahliae)、稻瘟病菌(Magnaporthe oryzae)、胶孢炭疽菌(Colletotrichum gloeosporioides)等多种病原真菌均具有良好的拮抗效果。 结论 洋葱伯克霍尔德氏菌KRS634菌株特性优异,在防治棉花红腐病等真菌病害方面具有较好的应用潜力,可作为开发棉花红腐病生防菌剂的候选菌株。
吴琼, 陈德勇, 朱鹤, 王丹, 张晓军, 陈捷胤. 洋葱伯克霍尔德氏菌KRS634对棉花红腐病的生防效果[J]. 生物技术通报, 2025, 41(12): 294-303.
WU Qiong, CHEN De-yong, ZHU He, WANG Dan, ZHANG Xiao-jun, CHEN Jie-yin. Biocontrol Effect of Burkholderia contaminans KRS634 on Cotton Red Rot Disease[J]. Biotechnology Bulletin, 2025, 41(12): 294-303.
级别 Grade | 分级标准 Grading standard | 级值 Value |
|---|---|---|
| 0级 | 无病状,健康植株 | 0 |
| 1级 | 下胚轴有少数小的病斑(褐色凹陷斑或红肿斑纹),病斑横向直径<下胚轴直径的1/4 | 1 |
| 2级 | 下胚轴病斑稍大,下胚轴直径的1/4≤病斑直径<下胚轴直径的1/2 | 2 |
| 3级 | 下胚轴病斑较大,下胚轴直径的1/2≤病斑直径<下胚轴直径的3/4,或下胚轴缢缩 | 3 |
| 4级 | 病斑直径>下胚轴直径的3/4,或整株萎蔫或死亡 | 4 |
表1 棉花红腐病的病情分级标准
Table 1 Grading standards for cotton red rot disease
级别 Grade | 分级标准 Grading standard | 级值 Value |
|---|---|---|
| 0级 | 无病状,健康植株 | 0 |
| 1级 | 下胚轴有少数小的病斑(褐色凹陷斑或红肿斑纹),病斑横向直径<下胚轴直径的1/4 | 1 |
| 2级 | 下胚轴病斑稍大,下胚轴直径的1/4≤病斑直径<下胚轴直径的1/2 | 2 |
| 3级 | 下胚轴病斑较大,下胚轴直径的1/2≤病斑直径<下胚轴直径的3/4,或下胚轴缢缩 | 3 |
| 4级 | 病斑直径>下胚轴直径的3/4,或整株萎蔫或死亡 | 4 |
编号 Number | 菌落直径平均值 Average colony diameter (mm) | 抑菌率 Inhibition rate (%) |
|---|---|---|
| CK | 68.03±0.52 | - |
| KRS504 | (35.90±0.97) a | (47.23±0.01) g |
| KRS507 | (32.38±0.47) b | (52.40±0.00) f |
| KRS515 | (31.91±0.20) b | (53.09±0.01) f |
| KRS516 | (21.37±0.56) cde | (68.59±0.01) cde |
| KRS523 | (20.02±0.37) ef | (70.57±0.00) bc |
| KRS524 | (22.44±1.06) c | (67.01±0.02) e |
| KRS620 | (17.99±0.14) g | (73.56±0.00) a |
| KRS625 | (19.36±0.75) f | (71.54±0.01) b |
| KRS631 | (21.71±0.79) cd | (68.09±0.01) de |
| KRS634 | (17.83±0.21) g | (73.80±0.00) a |
| KRS638 | (20.11±1.41) ef | (70.44±0.02) bc |
| KRS642 | (32.86±0.95) b | (51.70±0.01) f |
| KRS666 | (20.38±0.62) def | (70.04±0.01) bcd |
| KRS671 | (19.98±0.93) ef | (70.63±0.02) bc |
| KRS684 | (22.73±0.78) c | (66.59±0.01) e |
表2 不同菌株对拟轮枝镰孢霉的抑制效果
Table 2 Inhibitory effect of different antagonistic strains against F. verticillioides
编号 Number | 菌落直径平均值 Average colony diameter (mm) | 抑菌率 Inhibition rate (%) |
|---|---|---|
| CK | 68.03±0.52 | - |
| KRS504 | (35.90±0.97) a | (47.23±0.01) g |
| KRS507 | (32.38±0.47) b | (52.40±0.00) f |
| KRS515 | (31.91±0.20) b | (53.09±0.01) f |
| KRS516 | (21.37±0.56) cde | (68.59±0.01) cde |
| KRS523 | (20.02±0.37) ef | (70.57±0.00) bc |
| KRS524 | (22.44±1.06) c | (67.01±0.02) e |
| KRS620 | (17.99±0.14) g | (73.56±0.00) a |
| KRS625 | (19.36±0.75) f | (71.54±0.01) b |
| KRS631 | (21.71±0.79) cd | (68.09±0.01) de |
| KRS634 | (17.83±0.21) g | (73.80±0.00) a |
| KRS638 | (20.11±1.41) ef | (70.44±0.02) bc |
| KRS642 | (32.86±0.95) b | (51.70±0.01) f |
| KRS666 | (20.38±0.62) def | (70.04±0.01) bcd |
| KRS671 | (19.98±0.93) ef | (70.63±0.02) bc |
| KRS684 | (22.73±0.78) c | (66.59±0.01) e |

图5 拮抗细菌KRS634对棉花红腐病的防治效果A:棉花表型; a-d:棉花正视图;e-h:棉花俯视图;i-l:棉花根部表型;B:棉花病株率;C:棉花病情指数;*表示对照组和处理组在P<0.05水平上差异显著(t检验), ***表示对照组和处理组在P<0.001水平上差异显著(t检验),下同
Fig. 5 Biocontrol effect of antagonistic bacteria KRS634 on cotton red rot diseaseA: Cotton phenotype. a-d: Front view of cotton; e-h: top view of cotton; i-l: root phenotype of cotton. B: Rate of diseased cotton plants. C: Disease index of cotton; * indicates a significant difference between the control group and the treatment group at the P<0.05 level (t-test), and *** indicates a significant difference between the control group and the treatment group at the P<0.001 level (t-test). The same below
株高 | 氮含量 | ||||
|---|---|---|---|---|---|
| 清水对照 CK | 12.80±1.76 | 0.14±0.04 | 1.04±0.41 | 3.80±1.09 | 3.98±1.72 |
| 菌液浇灌 Irrigationn with bacterial liquid | 14.41±2.16*** | 0.17±0.04** | 1.81±0.40*** | 5.39±0.68*** | 5.43±1.72** |
表3 KRS634对棉花生长情况的影响
Table 3 Impact of KRS634 on the growth situation of cotton plants
株高 | 氮含量 | ||||
|---|---|---|---|---|---|
| 清水对照 CK | 12.80±1.76 | 0.14±0.04 | 1.04±0.41 | 3.80±1.09 | 3.98±1.72 |
| 菌液浇灌 Irrigationn with bacterial liquid | 14.41±2.16*** | 0.17±0.04** | 1.81±0.40*** | 5.39±0.68*** | 5.43±1.72** |
图6 KRS634对7种病原真菌生长抑制的平板对峙结果A: 菌落生长表型; B: 菌落直径; C: 菌落抑制率; ****表示对照组和处理组在P<0.000 1水平上差异显著(t检验),下同
Fig. 6 Results of KRS634 against seven pathogenic fungi using the plate confrontation methodA: Phenotype of colony growth. B: Colony diameter. C: Bacterial colony inhibition rate. **** indicates the significant differences between control group and treatment group at P<0.000 1 level (t test), the same below
图7 KRS634挥发性有机化合物对7种病原真菌的广谱抑制作用
Fig. 7 Broad-spectrum inhibitory effect of volatile organic compounds released from KRS634 against seven pathogenic fungi
| [1] | 陈常兵. 我国内地棉区棉花生产现状与发展对策 [J]. 中国农技推广, 2022, 38(10): 10-13. |
| Chen CB. Present situation and development countermeasures of cotton production in China's inland cotton areas [J]. China Agric Technol Ext, 2022, 38(10): 10-13. | |
| [2] | Qanmber G, Liu Z, Li FG, et al. Brassinosteroids in cotton: orchestrating fiber development [J]. New Phytol, 2024, 244(5): 1732-1741. |
| [3] | 刘梦丽. 两种棉花苗期病害病原菌毒素致病机理及种衣剂研制 [D]. 乌鲁木齐: 新疆农业大学, 2020. |
| Liu ML. Pathogenic mechanism of two kinds of cotton seedling diseases caused by toxin and preparation of seed coating agent [D]. Urumqi: Xinjiang Agricultural University, 2020. | |
| [4] | 李玉红. 棉花苗期病害综合防治技术 [J]. 河南农业, 2013(9): 29. |
| Li YH. Integrated control techniques of cotton seedling diseases [J]. Agric Henan, 2013(9): 29. | |
| [5] | Omotayo OP, Babalola OO. Corrigendum: Fusarium verticillioides of maize plant: Potentials of propitious phytomicrobiome as biocontrol agents [J]. Front Fungal Biol, 2023, 4: 1298350. |
| [6] | Blacutt AA, Gold SE, Voss KA, et al. Fusarium verticillioides: advancements in understanding the toxicity, virulence, and niche adaptations of a model mycotoxigenic pathogen of maize [J]. Phytopathology, 2018, 108(3): 312-326. |
| [7] | Moebus S, Boedeker W. Case fatality as an indicator for the human toxicity of pesticides—a systematic scoping review on the availability and variability of severity indicators of pesticide poisoning [J]. Int J Environ Res Public Health, 2021, 18(16): 8307. |
| [8] | Rangasamy K, Athiappan M, Devarajan N, et al. Pesticide degrading natural multidrug resistance bacterial flora [J]. Microb Pathog, 2018, 114: 304-310. |
| [9] | Wang D, Luo WZ, Zhang DD, et al. Insights into the biocontrol function of a Burkholderia gladioli strain against Botrytis cinerea [J]. Microbiol Spectr, 2023, 11(2): e04805-22. |
| [10] | 王琪, 胡哲, 富薇, 等. 伯克霍尔德氏菌GD17对黄瓜幼苗耐干旱的调节 [J]. 生物技术通报, 2023, 39(3): 163-175. |
| Wang Q, Hu Z, Fu W, et al. Regulation of Burkholderia sp. GD17 on the drought tolerance of cucumber seedlings [J]. Biotechnol Bull, 2023, 39(3): 163-175. | |
| [11] | 许萌杏, 李凤芳, 袁高庆, 等. 洋葱伯克霍尔德氏菌JX-1防治番茄青枯病机理的初步分析 [J]. 中国生物防治学报, 2021, 37(2): 304-314. |
| Xu MX, Li FF, Yuan GQ, et al. Identification and characterization of Burkholderia cepacia JX-1 against the tomato bacterial wilt [J]. Chin J Biol Control, 2021, 37(2): 304-314. | |
| [12] | Heo AY, Koo YM, Choi HW. Biological control activity of plant growth promoting rhizobacteria Burkholderia contaminans AY001 against tomato Fusarium wilt and bacterial speck diseases [J]. Biology, 2022, 11(4): 619. |
| [13] | Zaman NR, Chowdhury UF, Reza RN, et al. Plant growth promoting endophyte Burkholderia contaminans NZ antagonizes phytopathogen Macrophomina phaseolina through melanin synthesis and pyrrolnitrin inhibition [J]. PLoS One, 2021, 16(9): e0257863. |
| [14] | 吴丽娟, 韩聪, 王惠梅, 等. 伯克霍尔德氏菌JP2-270抗水稻纹枯病菌机理的初步研究 [J]. 中国生物防治学报, 2022, 38(1): 230-241. |
| Wu LJ, Han C, Wang HM, et al. Study on the resistance mechanism of Burkholderia sp. JP2-270 against rice sheath blight [J]. Chin J Biol Control, 2022, 38(1): 230-241. | |
| [15] | Esmaeel Q, Jacquard C, Clément C, et al. Genome sequencing and traits analysis of Burkholderia strains reveal a promising biocontrol effect against grey mould disease in grapevine (Vitis vinifera L.) [J]. World J Microbiol Biotechnol, 2019, 35(3): 40. |
| [16] | Esmaeel Q, Jacquard C, Sanchez L, et al. The mode of action of plant associated Burkholderia against grey mould disease in grapevine revealed through traits and genomic analyses [J]. Sci Rep, 2020, 10: 19393. |
| [17] | 王明元, 徐志周, 刘建福, 等. 伯克霍尔德菌HQB-1抑制香蕉枯萎病菌的活性化合物分离鉴定 [J]. 微生物学通报, 2021, 48(6): 1965-1975. |
| Wang MY, Xu ZZ, Liu JF, et al. Isolation and identification of bioactive compounds of Burkholderia HQB-1 strain inhibiting banana wilt [J]. Microbiol China, 2021, 48(6): 1965-1975. | |
| [18] | 蒋宝贵, 赵斌. 解磷解钾自生固氮菌的分离筛选及鉴定 [J]. 华中农业大学学报, 2005, 24(1): 43-48. |
| Jiang BG, Zhao B. Screening and identification of the bacterium which have high efficiency on resolving phosphorus and potassium and in nitrogen fixation [J]. J Huazhong Agric Univ, 2005, 24(1): 43-48. | |
| [19] | 唐梦瑜. 沙雷氏菌KRS006对棉花黄萎病的防效及抑菌机制研究 [D]. 牡丹江: 牡丹江师范学院, 2024. |
| Tang MY. Study on the control effect and antibacterial mechanism of Serratia KRS006 against Cotton Verticillium Wilt [D]. Mudanjiang: Mudanjiang Normal University, 2024. | |
| [20] | 东秀珠, 蔡妙英. 常见细菌系统鉴定手册 [M]. 北京: 科学出版社, 2001. |
| Dong XZ, Cai MY. Handbook of identification of common bacterial systems [M]. Beijing: Science Press, 2001. | |
| [21] | 布坎南(R.E.Buchanan),中国科学院微生物研究所《伯杰细菌鉴定手册》翻译组译. 伯杰细菌鉴定手册第八版 [M]. 8版. 北京: 科学出版社, 1984. |
| Buchanan RE, Chinese academy of sciences institute of microbiology, translated. 8th Edition. Bergey's manual of determinative bacteriology [M]. 8th ed. Beijing: Science Press, 1984. | |
| [22] | 王信, 程亮, 王亚艺, 等. 一种由山葵果胶杆菌引起的马铃薯细菌性软腐病 [J]. 西南农业学报, 2018, 31(7): 1386-1392. |
| Wang X, Cheng L, Wang YY, et al. Bacterial soft rot disease of Solanum tuberosum L. by Pectobacterium wasabiae [J]. Southwest China J Agric Sci, 2018, 31(7): 1386-1392. | |
| [23] | 萨吉达木·艾则孜, 麦合木提江·米吉提, 许泰百, 等. 新疆棉花主栽品种对2种棉花苗期病害抗性分析 [J]. 新疆农业科学, 2018, 55(6): 1133-1143. |
| Sajidamu AZZ, Mahemutijiang MJT, Xu TB, et al. Analysis of resistance of the main cotton cultivars to two seedling diseases in Xinjiang [J]. Xinjiang Agric Sci, 2018, 55(6): 1133-1143. | |
| [24] | 许泰百. 四种棉花土传病害侵染动态及兼防药剂筛选 [D]. 乌鲁木齐: 新疆农业大学, 2019. |
| Xu TB. Dynamics of four soil-borne diseases on cotton and screening of fungicides against them [D]. Urumqi: Xinjiang Agricultural University, 2019. | |
| [25] | 罗万珍, 王丹, 齐宏玥, 等. 拮抗细菌KRS022的鉴定及对大丽轮枝菌的抑制效果 [J]. 中国农业科学, 2023, 56(4): 649-664. |
| Luo WZ, Wang D, Qi HY, et al. Identification of antagonistic bacterium strain KRS022 and its inhibition effect on Verticillium dahliae [J]. Sci Agric Sin, 2023, 56(4): 649-664. | |
| [26] | 卫鑫辰, 王巧, 石彬, 等. 新洋葱伯克霍尔德氏菌YM12的分离鉴定及其对黄瓜软腐病的防治效果 [J]. 中国生物防治学报, 2024, 40(5): 1088-1098. |
| Wei XC, Wang Q, Shi B, et al. Isolation and identification of Burkholderia cenocepacia YM12 and its control effect on cucumber soft rot disease [J]. Chin J Biol Control, 2024, 40(5): 1088-1098. | |
| [27] | 马白鸽, 魏喜红, 孟祥佳, 等. 伯克霍尔德氏菌在植物病害生物防治中的研究进展 [J]. 农业研究与应用, 2023, 36(3): 1-8. |
| Ma BG, Wei XH, Meng XJ, et al. Advancements in study on Burkholderia for plant disease biocontrol [J]. Agric Res Appl, 2023, 36(3): 1-8. | |
| [28] | 闵莉静, 郭璐, 叶建仁. 基于嗜铁素介导的吡咯伯克霍尔德氏菌JK-SH007促生作用机制研究 [J]. 南京林业大学学报: 自然科学版, 2019, 43(6): 165-172. |
| Min LJ, Guo L, Ye JR. Mechanism of Burkholderia pyrrocinia JK-SH007 growth-promoting to plant via siderophore-mediation [J]. J Nanjing For Univ Nat Sci Ed, 2019, 43(6): 165-172. | |
| [29] | 刘小雪, 黄美壬, 唐晓琳, 等. 一株烟草生防菌的鉴定及防病促生作用分析 [C]//中国植物病理学会2023年学术年会论文集. 泰安, 2023: 659. |
| Liu XX, Huang MR, Tang XL, et al. Identification of a biological control bacterium for tobacco and analysis of its disease prevention and growth promotion effects [C]. Proceedings of the 2023 Annual Academic Conference of the Chinese Society of Plant Pathology. 2023: 659. | |
| [30] | Gao YH, Feng J, Wu JF, et al. Transcriptome analysis of the growth-promoting effect of volatile organic compounds produced by Microbacterium aurantiacum GX14001 on tobacco (Nicotiana benthamiana) [J]. BMC Plant Biol, 2022, 22(1): 208. |
| [31] | Kong WL, Li PS, Wu XQ, et al. Forest tree associated bacterial diffusible and volatile organic compounds against various phytopathogenic fungi [J]. Microorganisms, 2020, 8(4): 590. |
| [32] | Toral L, Rodríguez M, Martínez-Checa F, et al. Corrigendum: Identification of volatile organic compounds in extremophilic bacteria and their effective use in biocontrol of postharvest fungal phytopathogens [J]. Front Microbiol, 2023, 14: 1267324. |
| [33] | Luo H, Riu M, Ryu CM, et al. Volatile organic compounds emitted by Burkholderia pyrrocinia CNUC9 trigger induced systemic salt tolerance in Arabidopsis thaliana [J]. Front Microbiol, 2022, 13: 1050901. |
| [34] | Chen JH, Xiang W, Cao KX, et al. Characterization of volatile organic compounds emitted from endophytic Burkholderia cenocepacia ETR-B22 by SPME-GC-MS and their inhibitory activity against various plant fungal pathogens [J]. Molecules, 2020, 25(17): 3765. |
| [35] | Liu AK, Zhang PF, Bai BX, et al. Volatile organic compounds of Endophytic Burkholderia pyrrociniaStrain JK-SH007 promote disease resistance in poplar [J]. Plant Dis, 2020, 104(6): 1610-1620. |
| [36] | Bakhtiyarifar M, Enayatizamir N, Mehdi Khanlou K. Biochemical and molecular investigation of non-rhizobial endophytic bacteria as potential biofertilisers [J]. Arch Microbiol, 2021, 203(2): 513-521. |
| [37] | Kong P, Hong CX. Endophytic Burkholderia sp. SSG as a potential biofertilizer promoting boxwood growth [J]. PeerJ, 2020, 8: e9547. |
| [1] | 贾雪, 隋丽, 邹晓威, 路杨, 张正坤, 李启云. 真菌病毒BbOCuV1对寄主球孢白僵菌生长发育和亚洲玉米螟致病力的影响[J]. 生物技术通报, 2025, 41(7): 312-325. |
| [2] | 张吉昌, 许云凤, 蒋凌雁. 柱花草内生细菌ZW21发酵条件优化及其抑菌物质稳定性测定[J]. 生物技术通报, 2025, 41(5): 280-289. |
| [3] | 慕雪男, 吴桐, 郑子薇, 张越, 王志刚, 徐伟慧. 一株番茄青枯病生防细菌的筛选、鉴定及其生防潜力分析[J]. 生物技术通报, 2025, 41(1): 276-286. |
| [4] | 刘倩, 马连杰, 张慧, 王冬, 范茂, 廖敦秀, 赵正武, 卢文才. 辣椒炭疽病生防菌株TN2的筛选鉴定与抑菌效果[J]. 生物技术通报, 2025, 41(1): 287-297. |
| [5] | 王美玲, 耿丽丽, 房瑜, 束长龙, 张杰. 苏云金芽胞杆菌4BM1菌株对油菜菌核病的防治潜力[J]. 生物技术通报, 2024, 40(9): 260-269. |
| [6] | 王芳, 于璐, 齐泽铮, 周长军, 于吉东. 大豆镰刀菌根腐病拮抗菌的筛选及生防效果[J]. 生物技术通报, 2024, 40(7): 216-225. |
| [7] | 范宗强, 冯靖涵, 郑丽雪, 王硕, 彭向前, 陈芳. 枯草芽孢杆菌B579对黄瓜枯萎病的防治及其诱导抗性研究[J]. 生物技术通报, 2024, 40(7): 226-234. |
| [8] | 徐伟芳, 李贺宇, 张慧, 何仔昂, 高文恒, 谢紫洋, 王传文, 尹登科. 生防细菌HX0037对栝楼炭疽病的防病能力及其机制[J]. 生物技术通报, 2024, 40(4): 228-241. |
| [9] | 许沛冬, 易剑锋, 陈迪, 潘磊, 谢丙炎, 赵文军. 贝莱斯芽孢杆菌生防次级代谢产物研究进展[J]. 生物技术通报, 2024, 40(3): 75-88. |
| [10] | 丁艳哲, 姚鑫鑫, 孙卓, 杨利民, 韩忠明, 王云贺. 刺五加黑斑病生防细菌分离、鉴定、优选及发酵条件优化[J]. 生物技术通报, 2024, 40(12): 218-226. |
| [11] | 叶柳健, 贺愉岚, 王小虎, 韦圣博, 何双, 朱绮霞, 卢洁, 周礼芹. 解淀粉芽孢杆菌YK3对沃柑溃疡病的防效及叶际细菌群落相关性的影响[J]. 生物技术通报, 2024, 40(11): 248-258. |
| [12] | 李希, 边子俊, 宁周神, 刘红雨, 曾槟, 董伟. 离子型稀土矿根际芽孢杆菌的促生作用研究[J]. 生物技术通报, 2024, 40(11): 259-268. |
| [13] | 马云涛, 胡丽娜, 孙文婧, 唐莲庚, 孙思远, 邓欣雨, 孙黎. 梨火疫病拮抗菌JK2的筛选鉴定及发酵条件优化[J]. 生物技术通报, 2024, 40(11): 202-213. |
| [14] | 王俊芳, 黄秋斌, 张飘丹, 张彭湃. Surfactin的结构、生物合成及其在生物防治中的作用[J]. 生物技术通报, 2024, 40(1): 100-112. |
| [15] | 褚睿, 李昭轩, 张学青, 杨东亚, 曹行行, 张雪艳. 黄瓜枯萎病拮抗芽孢杆菌的筛选、鉴定及其生防潜力[J]. 生物技术通报, 2023, 39(8): 262-271. |
| 阅读次数 | ||||||
|
全文 |
|
|||||
|
摘要 |
|
|||||